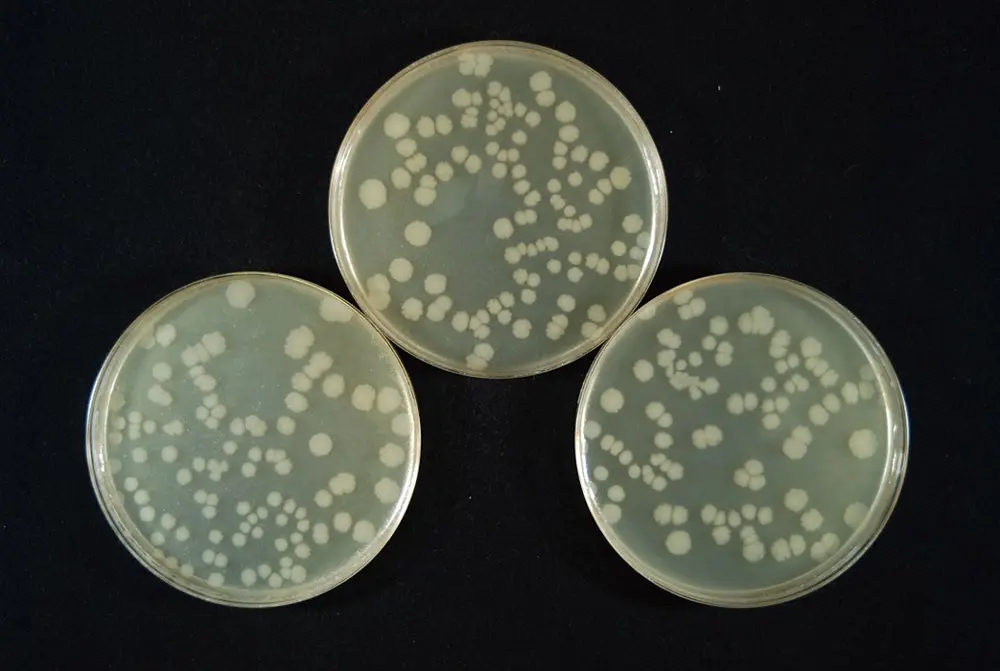
大腸菌生育状況
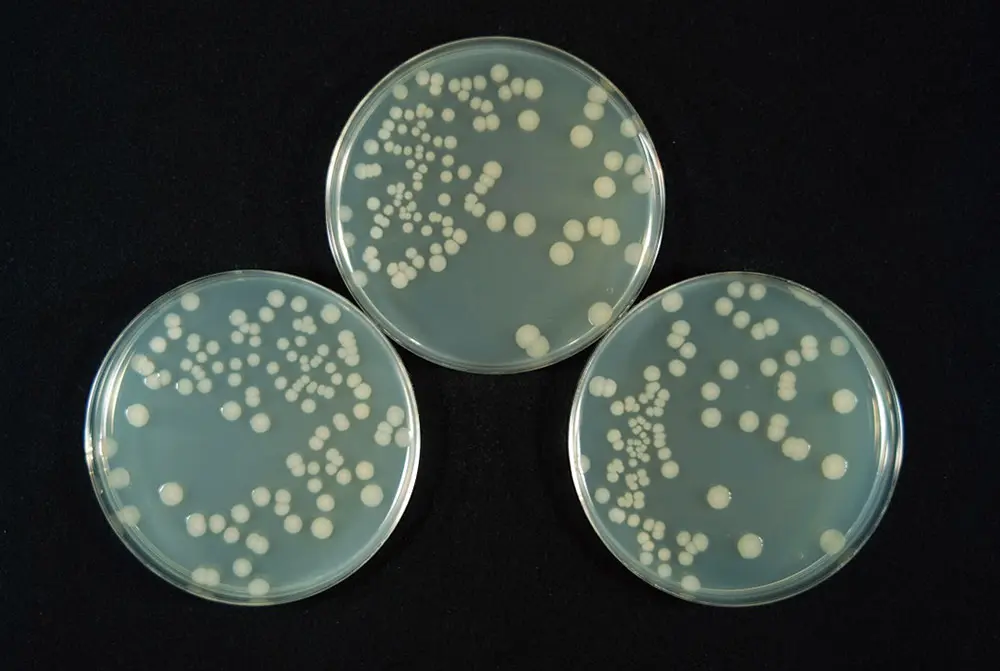
大腸菌生育状況
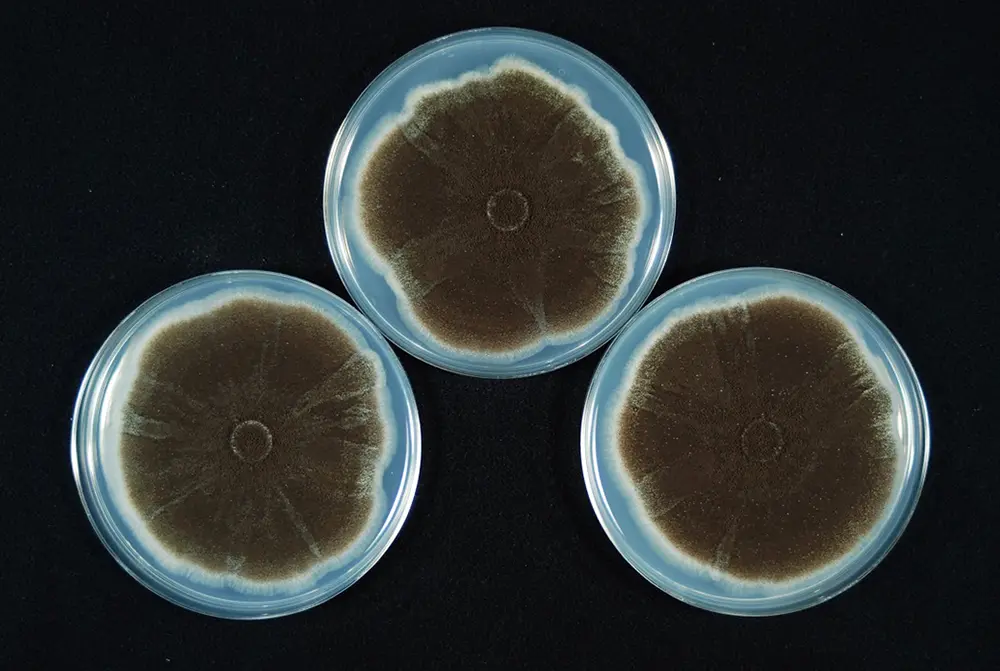

奈良県産のJAS製材品の特長
いつの時代も求められる
強くて美しい
奈良のJAS製材
品質、施工のしやすさに信頼のあるJAS製材品。
その中でも「奈良の木」は、その強さと美しさ、
科学的実証実験でも証明された全国でも類を見ない高付加価値があり、
多くの方を魅了しています。
「強くて美しい」奈良の木
世界の土地面積の約3割を占める森林。日本では国土の約6.7割、奈良県では県土の約7.7割が森林です。県南部の『吉野林業地域』は500年以上の歴史があり、足利末期(1500年頃)から造林が行われてきました。極端な密植、弱度の間伐を数多く繰り返し、長伐期とする集約的施業による、わが国有数の優良な生産地です。
『ヤング係数』の高さが数値により証明されています。
木材構造物を設計する際、構造材として使用される柱や梁等には一定の強度性能が必要となる場合があります。構造材の強度性能を評価する指標として、ヤング係数から求められる強度等級にはE50、E70、E90、E110などがあります。杉の全国データは、ヤング係数がE70を示すものが最多に対し、奈良県産材は大半がE90以上を示しています。
最新データからみる奈良県産材の強さ
奈良の木といえば、代表的なものが杉と桧ですが年輪幅が狭く密度が高いことから一般的な杉・桧に比べて強く、たわみにくい特徴を持ちます。木のたわみにくさを示す『ヤング係数』の調査では、奈良県産材が一般的な材よりも高い強度を示し、数値により証明されています。令和3年には『都市(まち)の木造化推進法』が施行され、民間建築物を含む建築物一般で木材利用を促進する方針が掲げられました。今後は、非住宅建築物(商業施設や、福祉施設等)の木造化が進むと期待されています。その際に、安心・安全に信頼のある奈良県産材がより一層評価されることでしょう。

節が少なく木目が均一、赤みがかった材の美しさ
古くは、大坂城築城の際も所望された奈良県産材はその育成方法の賜物です。細かく枝打ちを行い、綿密に計算された間伐を行うことで、通直で節が少なく均等な年輪、そして独特の上品な赤みを持つ木々に成長します。鴨居や床柱など、風格を表現する空間には欠かせない化粧材として全国から注文が殺到していました。今でも、そのなんとも得難い風合いが造作家具を中心に人気です。


実験で実証された奈良の木の健康効果について。
福祉施設、公共施設などの建築物に期待される健康効果
奈良県産材は全国各地から買い手がつくほど人気があります。香りがよい、強くたわみにくい、木目が美しいという特徴は前述の通りですが、近年は設計士や大工職人といったプロの間だけでなく、ユーザーにも「奈良の木の健康効果」について知れ渡るようになりました。特に、奈良県が行った科学的な検証は住環境を重視するユーザーにとって有益な結果となりました。

01_ウイルスの不活化

方法:インフルエンザウイルスA型と、木粉または鉄粉やポリプロピレンの粉を接触させた後、ウイルスの感染力を繰り返し3回測定
結果:奈良のスギ材70年生、ヒノキ材はウイルスの感染力を著しく低下
※抗ウイルス活性値は、値が大きいほど感染力のあるウイルスを減らす効果があることを示します。
02_ 大腸菌の抑制

方法: 寒天培地に大腸菌を吹きかけ、生育状況を2日間観察
結果: スギ精油では1% 添加で、ヒノキ精油では5%の添加で大腸菌の増殖を阻止
03_カビの生育抑制

方法: 寒天培地の中央にカビを植え付けて、生育状況を7日間観察
結果:奈良のスギ精油の添加で、カビの生育を完全に阻止
04_紫外線の軽減

方法:板材に光をあてて反射量を測定
結果:奈良のスギ材、ヒノキ材いずれも、白内障や加齢黄斑変性の原因とされる紫外線をほとんど完全に除去。目の疲れや睡眠障害を引き起こすブルーライトを軽減
05_ダニの忌避

方法:侵入したダニ(ヤケヒョウヒダニ)の数を3回測定
結果:奈良県のスギ材やヒノキ材に侵入したダニはカーペットの1/6~2/3。
非住宅建築等へのJAS構造材の活用を支援しています。
>> JAS構造材実証支援事業







